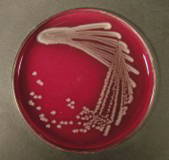

May 2025
Here is the latest from our farm team at Mount Vets. If you would like any further advice or would like us to cover something in the next newsletter, please call us on 01823 663384 or contact us here.
We want to hear your feedback… Leave us a review!
We value your feedback and comments and would appreciate if you could take the time to leave us a review! Please follow the link to share your thoughts.
Culture And Sensitivity
Next in the diagnostic testing series is bacterial culture and sensitivity. Most will think this method is only applicable to dairy cows with mastitis, but bacterial culture and sensitivity can be used in many other instances. For example, if a swab is taken from lungs affected by pneumonia at postmortem, culture and sensitivity will be able to provide guidance as to the most suitable antibiotic. It’s also used in disease outbreaks such as Salmonella infections to again direct our antibiotic choice to those that will work against the bacteria.
Firstly, a representative sample must be taken, any contamination will skew the sample leading to misleading results. So, for milk samples this means clean teats, clean gloves, sterile pot and good sampling technique.
The sample is then sent to the lab where they will ‘plate it up’. What this means is they will dip a sterile inoculation loop into the sample, and then gently drag it across the surface of the growth plate. The plate is then turned, and the loop is streaked again over the surface. The aim is to pick up smaller amounts of bacteria each time, and as you work around the plate the number of bacteria streaked onto the plate will get less. This means that once grown, individual colonies can be picked out for identification and further testing.
The plates that bacteria are grown on can vary in ingredients depending on what they are trying to find. Colouring agents are included which change in appearance depending on what the bacteria use as part of their metabolism. Other factors used for colony identification of the species include the colour and texture, conditions they can grow in (air versus no air), even the smell!
Once the above culturing is completed, the sensitivity testing is carried out. The isolated bacteria are then put on a plate alongside discs that are impregnated with the different types of antibiotics. Again, the plates are incubated to encourage bacterial growth and after a number of days checked to see progress. If the bacteria is resistant, it will be able to grow right up to the disc. Whereas if sensitive, the antibiotics will hold the bacteria at bay, preventing any further progress towards the discs. It is these antibiotics which we will use.
This is the main advantage of culture and sensitivity compared PCR testing (discussed last time). Furthermore, it will allow growth and identification of a range of species under the same test, rather than having to request different tests for different species. The main downside to culture and sensitivity is the delay associated with the time required to allow bacterial growth.
If you wish to discuss this diagnostic test and applicability to your stock, please call us and have a chat with a vet on how it could work best for your farm.
Lungworm
Written by Pippa White
With the grazing season in full swing, we may soon start seeing cases of Lungworm cropping up in cattle. The main risk period is between July and October, and grazing seasons can have more favourable conditions for the parasite leading to variation in severity between years.
Causes
Bovine lungworm is caused by the parasite Dictyocaulus viviparus and is also known as “Husk”. Infective larvae are eaten by cattle and then migrate through the gut to reside as adults in the lungs and airways. This migration causes damage leading to the clinical signs shown by infected cattle. The adult lungworm produces eggs which are coughed up and swallowed. The eggs hatch inside the gut of the cow and are passed out as larvae onto the pasture. These larvae then develop into their infective stage very quickly and can lead to rapid contamination of the pasture.
Clinical Signs and Diagnosis
Lungworm is most seen in first season grazers with no prior exposure but should be considered in any cattle out at grass who are showing signs of a persistent cough. Early signs include coughing after exercise and an increased breathing rate. This may develop into coughing even when resting, loss of condition and milk drop in dairy cows. If animals with no immunity are exposed to pasture with high levels of contamination, sudden death can occur.
We can diagnose Lungworm on dung samples; it is a different technique to a normal worm egg count that we can run overnight or send off to our external laboratory. A glove full of fresh dung is a good sample size.
A presumptive diagnosis can also be reached based on farm history, clinical signs being shown and response to treatment. Lungworm larvae can also be found in the airways of dead animals.
Treatment
Most of the wormers in use at the moment are effective against Lungworm in the UK, these include the yellow and clear drenches. Where there is an outbreak in a group, all animals within that group should be treated. Animals showing signs of severe respiratory distress should be examined by a vet before treatment. Treatment of animals with heavy burdens can lead to mass die off and a large inflammatory response. We can mitigate this by treating with anti-inflammatories such as Metacam or a steroid alongside the wormer if necessary.
Prevention
Where the is no history of Lungworm on farm, care should be taken to avoid introducing it with bought in animals. There should be a quarantine protocol in place, where bought in animals are isolated from home stock and treated with an effective wormer before being introduce to clean pasture.
On farms with a history of Lungworm, vaccination can be an effective method of control. First season grazers should receive a course of vaccination before turnout to provide protection for the grazing season. Second season grazers can also be affected if they were not exposed during their first grazing season and therefore did not develop any immunity.
Upcoming courses

DIY Articial Insemiation Course
Our next 4-day DIY AI course will run on 19th, 20th, 22nd & 23rd August 2024.
This DEFRA approved course is aimed at anyone who has no previous experience in the artificial insemination of cows.
The 4-day course is run by our experienced farm vet Rob Mangham and is full of theory and practical sessions to make sure you leave feeling confident and safe in all aspects of AI.
The cost of the course is £500 + VAT, with a £50+VAT deposit to secure your space.
(Deposit will be taken off final amount)
Please ring the practice to book your place on any of our courses on 01823 663384 or email farm@mountvets.com
Meet the Team!
We have an experienced & friendly team here at Mount Vets. You might already recognise a few faces but over the next few months we will reintroduce you to some of our excellent team. To read more and see more of the faces of Mount Vets visit our team page, and be sure to follow us on Instagram and Facebook.

Piers Pepperell
Director
Many of you will already know our Mount Vets Director Piers; but did you know he has appeared on tv show Blind Date with Cilla Black?
Piers loves to spend a free day with his two daughters and three dogs, surfing on the North Devon Coast.
His favourite vet call out was when he was called into the waiting room and unknown to him at the time, but he then met his wife to be. She had brought in her eight baby bunny rabbits, which led on naturally to a 10-minute chat about pig wormers and her asking Piers out on a date.

Pip White
Vet
Pip is one of our large animal vets. If you’ve met her, you will probably know how much she loves her cows. So much so, that she loves to spend her free time at home with her cows! That, or in the showring showing them. 🐮
Pip graduated as top student in her year from the University of Surrey.
Her favourite song is Mr Brightside by the Killers.
Have a question about any of the topics covered in this newsletter?
If you need any assistance with the topics covered in this newsletter, please do not hesitate to get in touch with our experienced farm vets who will be able to help. Call 01823 663384, or contact us here.